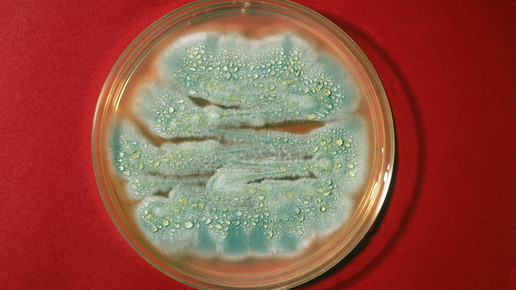

Interaktionen und Nebenwirkungen: Antibiotika Teil 2
Kommen bei einer bakteriell bedingten Infektion Antibiotika zum Einsatz, so können je nach Wirkstoff Interaktionen mit anderen Arzneimitteln auftreten. Nachdem in Teil 1 die Wirkweisen, Dosierungen und Nebenwirkungen behandelt wurden, geht dieser zweite Teil darauf ein, welche Einnahmehinweise bei den jeweiligen Wirkstoffen zu beachten sind.
Beta-Lactam-Antibiotika
Penicillin V:
Die gleichzeitige Einnahme des Gicht-Therapeutikums Probenecid führt zu einer Hemmung der renalen Penicillin-Ausscheidung. Der Wirkstoff verbleibt somit länger in Serum und Galle. Ebenso führen Indometacin, Salicylate und Sulfinpyrazon (Gicht) zu einer verlangsamten Wirkstoffausscheidung. Die gleichzeitige Einnahme von Tetracyclinen kann die bakterizide Wirkung von Penicillin V hemmen. Unter der Einnahme von Penicillin sollte ein zusätzlicher Verhütungsschutz zu oralen Kontrazeptiva angewendet werden.
Amoxicillin:
Neben Probenecid wird in der Fachinformation auch Allopurinol als Inhibitor der renalen Amoxicillin-Ausscheidung genannt. Die gleichzeitige Einnahme von Tetracyclinen kann die bakterizide Wirkung von Amoxicillin hemmen. Die Ausscheidung von Methotrexat (MTX) kann verringert werden – eine Erhöhung der Toxizität ist möglich.
Cephalosporine
Cefuroxim:
Die gleichzeitige Einnahme von Medikamenten gegen Sodbrennen kann die Bioverfügbarkeit von Cefuroxim vermindern. Probenecid verlangsamt die Ausscheidung des Wirkstoffes. Die gleichzeitige Einnahme von Antikoagulantien kann zu einem erhöhten INR-Wert führen (International Normalized Ratio; Verfahren zur Überprüfung der plasmatischen Blutgerinnung).
Tetrazykline
Doxycyclin:
Die Resoprtion kann durch zwei- oder dreiwertige Kationen verringert werden. Antazida, Eisenpräparate oder andere Mineralstoffpräparate sollten mindestens zwei Stunden versetzt eingenommen werden. Die Einnahme sollte nicht mit Milch erfolgen. Barbiturate und andere antikonvulsiv wirkende Arzneimittel (Carbamazepin, Primidon) können den Abbau von Doxycyclin beschleunigen. Chronischer Alkoholabusus kann ebenfalls zu einer schnelleren Elimination führen. Der Wirkstoff beeinflusst außerdem die Wirkung oraler Antidiabetika sowie die Wirkung von Antikoagulantien – eine Überprüfung der Blutzucker- und Blutgerinnungswerte sollte während der Einnahme erfolgen. Die toxische Wirkung von Ciclosporin kann erhöht werden. Findet eine Isotretinoin-Behandlung statt, so sollte ein anderes Antibiotikum eingesetzt werden. Es kann zur Drucksteigerung in der Schädelhöhle kommen. Bei gleichzeitiger Einnahme von Lithiumkann es zu Verwirrtheit kommen. Tetrazykline sollten nicht mit Beta-Laktam-Antibiotika kombiniert werden.
Makrolide
Azithromycin, Roxithromycin, Clarithromycin:
Bei gleichzeitiger Einnahme von Antikoagulantien sollten die Blutgerinnungswerte während der Einnahme beobachtet werden. Makrolide können die toxische Wirkung von Ciclosporin erhöhen. Werden gleichzeitig QT-Intervall-verlängernde Substanzen eingenommen, ist besondere Vorsicht geboten. Hierzu gehören unter anderem Antiarrhythmika wie Amiodaron, trizyklische Antidepressiva und Citalopram sowie gewisse Neuroleptika, Antimykotika und antivirale Wirkstoffe.
Gyrasehemmer (Chinolone & Fluorchinolone)
Ofloxacin, Levofloxacin,Ciprofloxacin:
Die Resorption kann durch zwei- oder dreiwertige Kationen verringert werden. Antazida, Eisen- und Zinkpräparate sollten mindestens zwei Stunden versetzt eingenommen werden. Die Einnahme sollte nicht mit Milch erfolgen. Die Einnahme der komplexen Aluminium-Verbindung Sucralfat (Indikation: Magengeschwür) sollte ebenfalls im Abstand von zwei Stunden erfolgen. Bei gleichzeitiger Einnahme von nichtsteroidalen Antiphlogistika oder Theophyllin kann es zu einer herabgesetzten Krampfschwelle kommen. Die renale Ausscheidung von Chinolonen und Fluorchinolonen wird durch Probenecid und Cimetidin (H2-Antagonist) reduziert.
Weitere Antibiotika
Fosfomycin:
Bei gleichzeitiger Einnahme von Metoclopramid kommt es zu einer verringerten Fosfomycin-konzentration im Serum. Die Einnahme sollte mindestens zwei Stunden zeitversetzt stattfinden. Nahrung kann die Resorption verzögern – eine Einnahme auf nüchternen Magen wird empfohlen. Bei der gleichzeitigen Einnahme von Vitamin-K-Antagonisten sollten die INR-Werte beobachtet werden.
Antibiotika und Nahrung
Interaktionen zwischen Antibiotika und Nahrungsmitteln lassen sich in pharmakokinetische (Resorption, Metabolisierung, Verteilung, Ausscheidung) und pharmakodynamische Wechselwirkungen unterteilen. Nahrung führt bei Arzneistoffen zu einer längeren Verweildauer im Magen, durch fettreiche Speisen kann dieser Effekt noch verstärkt werden. Der Magen ist aufgrund seiner großen Oberfläche ein Hauptresorptionsort für viele Arzneistoffe. Säurelabile Wirkstoffe (insbesondere Erythromycin) werden durch die längere Verweildauer stärker zersetzt. Andere Arzneistoffe können schwerlösliche Komplexe mit mehrwertigen Metallionen bilden.
Die Einnahme der meisten Antibiotika sollte vor den Mahlzeiten erfolgen, dies gilt insbesondere für Penicilline – die Bioverfügbarkeit von Penicillin V und Amoxicillin ist stark vom Füllgrad des Magens abhängig. Durch eine Einnahme vor dem Essen ergibt sich zusätzlich eine kürzere Verweildauer im Darm – die körpereigene Darmflora wird weniger geschädigt. Da einige Antibiotika Komplexe mit Metallionen bilden, sollte die Einnahme nur mit Leitungswasser erfolgen. Von Milch und Heilwässern mit hohem Mineralstoffgehalt (insbesondere Calcium) ist abzuraten.